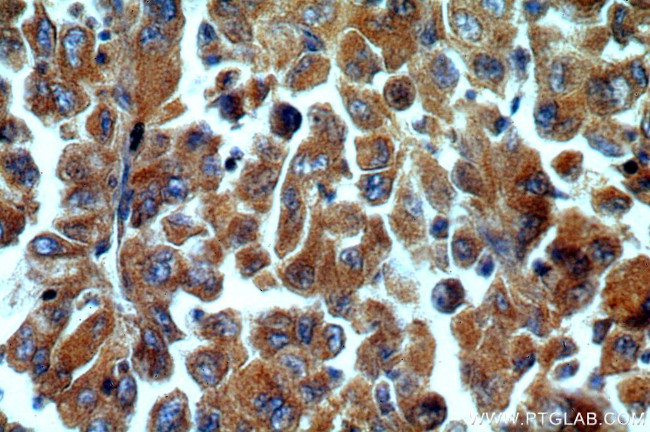
C9orf156 Antibody in Immunohistochemistry (Paraffin) (IHC (P))

Search
Proteintech
C9orf156 Polyclonal Antibody
{{$productOrderCtrl.translations['antibody.pdp.commerceCard.promotion.promotions']}}
{{$productOrderCtrl.translations['antibody.pdp.commerceCard.promotion.viewpromo']}}
{{$productOrderCtrl.translations['antibody.pdp.commerceCard.promotion.promocode']}}: {{promo.promoCode}} {{promo.promoTitle}} {{promo.promoDescription}}. {{$productOrderCtrl.translations['antibody.pdp.commerceCard.promotion.learnmore']}}
产品信息
20475-1-AP
种属反应
宿主/亚型
分类
类型
抗原
偶联物
形式
浓度
规格
纯化类型
保存液
内含物
保存条件
运输条件
产品详细信息
Immunogen sequence: NGHLSCKAK VQPPRLNGAK TGVFSTRSPH RPNAIGLTLA KLEKVEGGAI YLSGIDMIHG TPVLDIKPYI AEYDSPQNVM EPLADFNLQN NQHTPNTVSQ SDSKTDSCDQ RQLSGCDEPQ PHHSTKRKPK CPEDRTSEEN YLTHSDTARI QQAFPMHREI AVDFGLESRR DQSSSVAEEQ IGPYCPEKSF SEKGTDKKLE RVEGAAVLQG SRAETQPMAP HCPAGRADGA PRSVVPAWVT EAPVATLEVR FTPHAEMDLG QLSSQDVGQA SFKYFQSAEE AKRAIEAVLS ADPRSVYRRK LCQDRLFYFT VDIAHVTCWF GDGFAEVLRI KPASEPVHMT GPVGSLVSLG S (92-441 aa encoded by BC002863)
靶标信息
S-adenosyl-L-methionine-dependent methyltransferase responsible for the addition of the methyl group in the formation of N6-methyl-N6-threonylcarbamoyladenosine at position 37 (m(6)t(6)A37) of the tRNA anticodon loop of tRNA(Ser)(GCU) (PubMed:25063302). The methyl group of m(6)t(6)A37 may improve the efficiency of the tRNA decoding ability. May bind to tRNA. [UniProt]
仅用于科研。不用于诊断过程。未经明确授权不得转售。
篇参考文献 (0)
生物信息学
蛋白别名: Nef (lentivirus myristoylated factor) associated protein 1; Nef associated protein 1; nef-associated protein 1; thioesterase NAP1; tRNA (adenine(37)-N6)-methyltransferase; tRNA methyltransferase O; unnamed protein product
基因别名: C9orf156; HSPC219; NAP1; TRMO
UniProt ID: (Human) Q9BU70
Entrez Gene ID: (Human) 51531